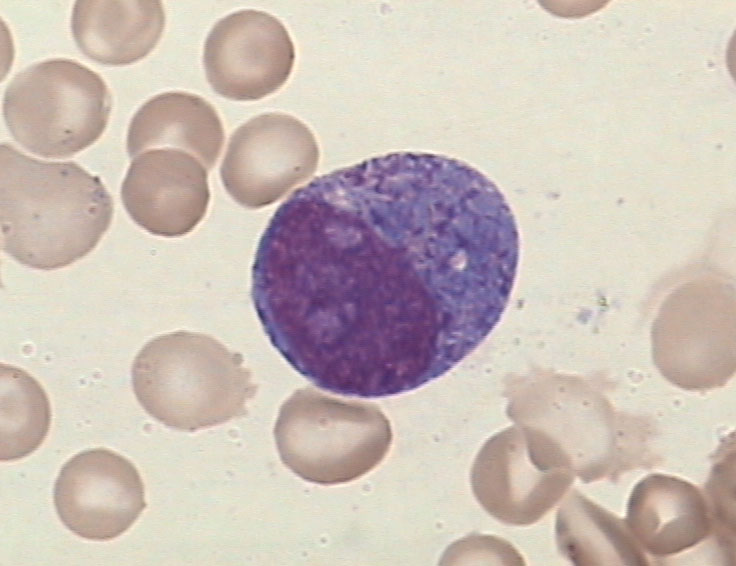
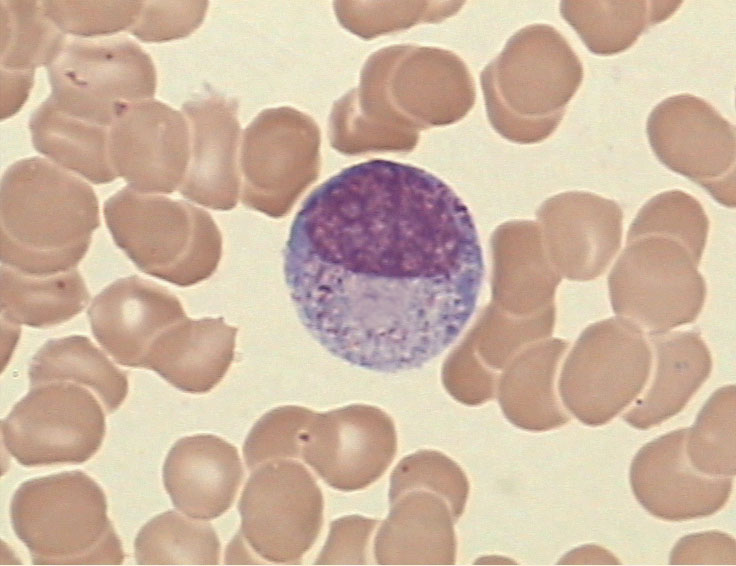
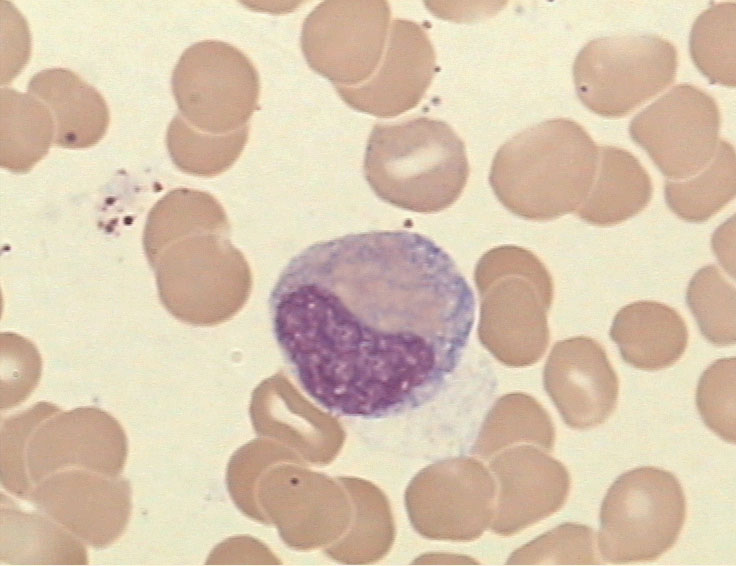
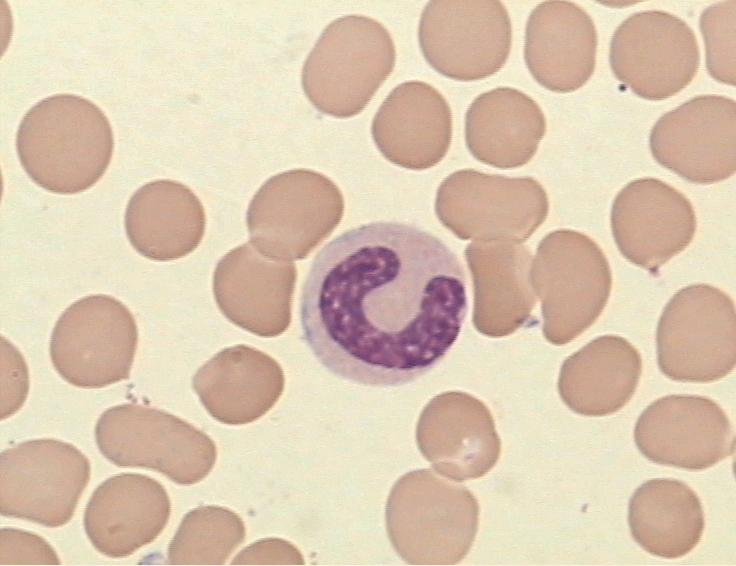
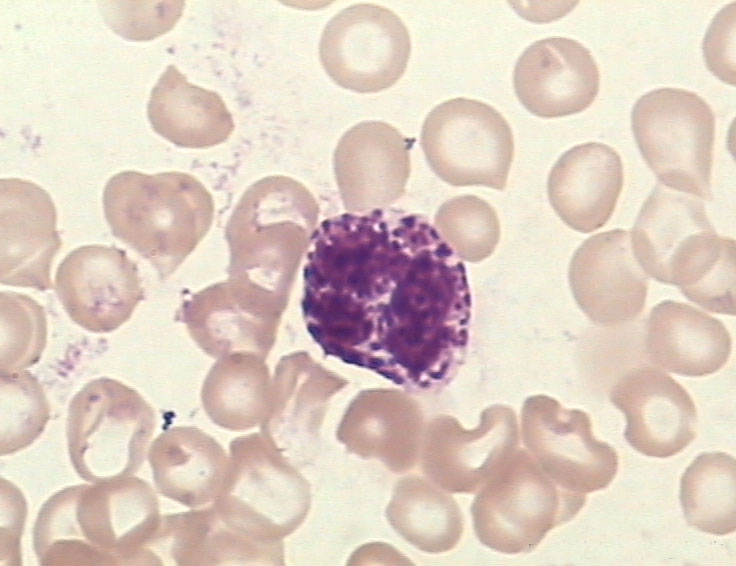
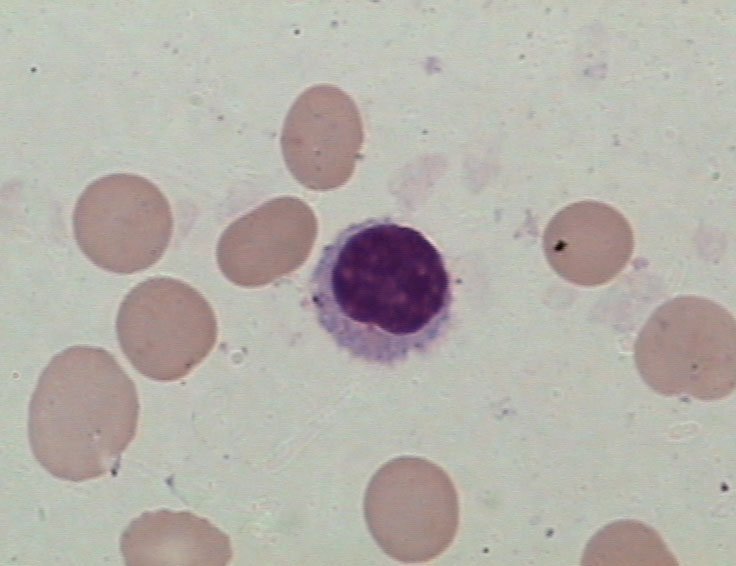
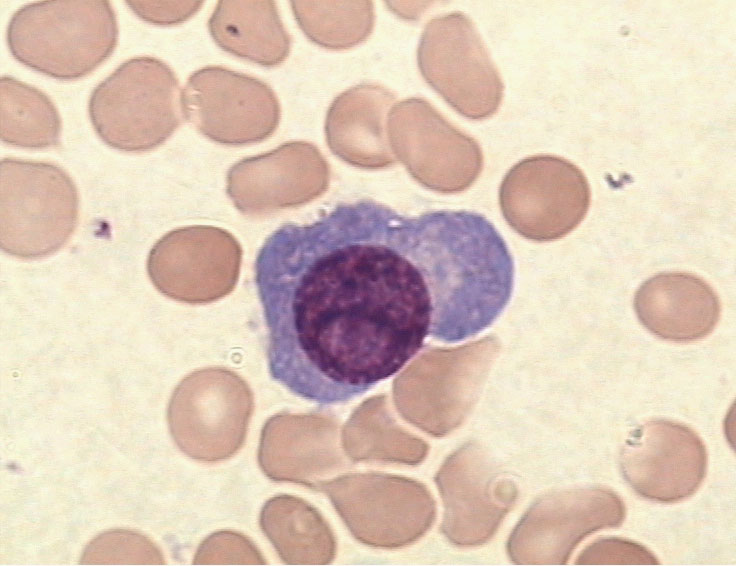
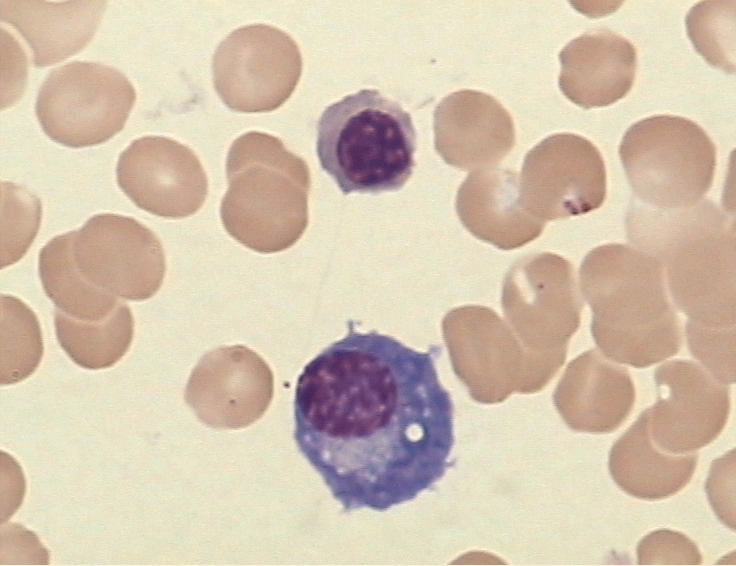
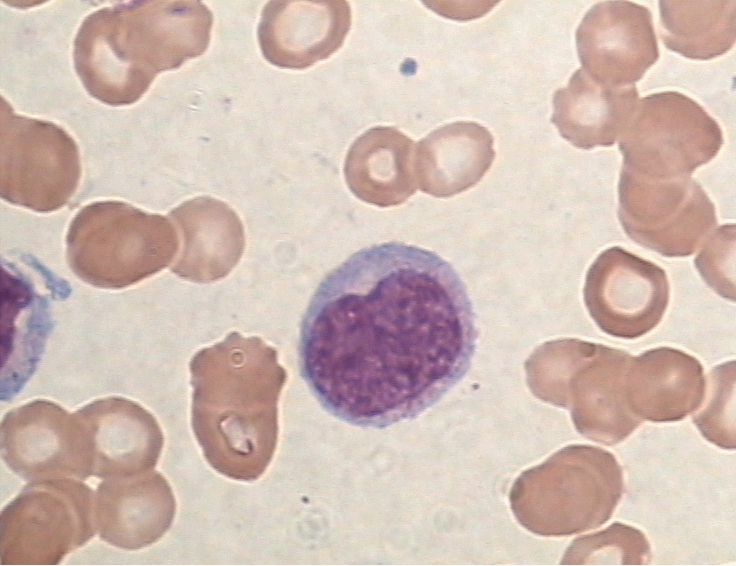
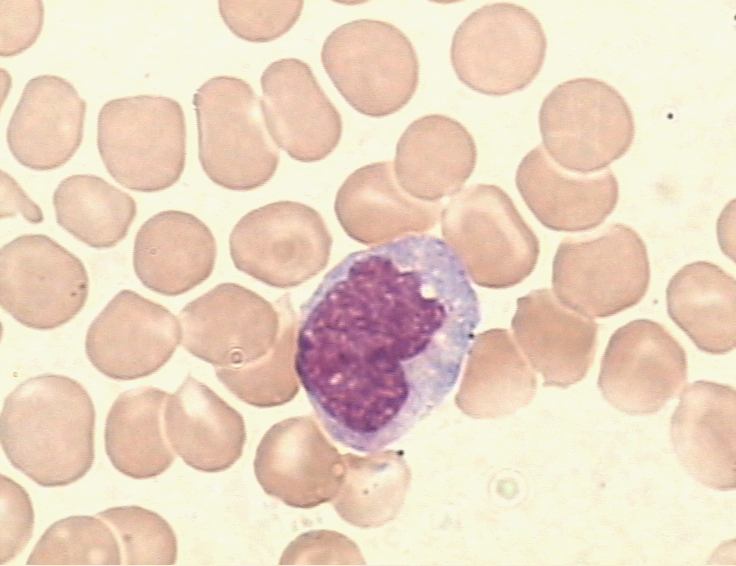

职称:副教授
主讲教师:胡梅琮
教师团队:共6位
| 学校: | 杭州医学院 |
| 开课院系: | 检验医学院 |
| 课程编号: | 3301002 |
| 学分: | 4.5 |
| 课时: | 96 |
血液学检验(hematologic laboratory science)是医学检验技术专业的一门专业核心课程,是以检验方法为手段,分析和研究血液和造血器官的病理变化,阐述血液系统疾病的发病机制,协助诊断、疗效观察和预后监测的一门学科。它既属于血液学范畴,又属于检验医学的一个分支。实际上,它是以血液学的理论为基础,以检验学的方法为手段,以临床血液病为工作对象,创建了一个理论-检验-疾病相互结合、紧密联系的新体系,并且在实践过程中不断发展、完善和提高。课程内容主要包括造血检验、红细胞疾病检验及其应用、白细胞疾病检验及其应用和血栓与止血检验及其应用等四个方面。在检验医学领域占有重要的地位。
1、用传统教学、多媒体教学、形态学图片资源库辅助教学系统等不同的教学手段。
2、引入开放式教学方式,完成“病例引导,任务驱动”理实一体教学过程。
3、建立与职业考试接轨的试题库。
4、实验教学考核评价为专业核心技能考核和综合技能考核相结合;实习考核为行业和学校教师共同完成。
5、鼓励和组织学生参加各级各类技能、创业等竞赛。

1、院校合作,确定血液学检验教学目标和教学内容。开展检验岗位基本情况调研,明确血液学检验及相关岗位职责和任务,确定完成岗位工作时应具备的职业素质和职业能力,结合根据国家卫生部、人事部组织的专业技术资格考试大纲要求,确定血液学检验教学目标和教学内容。
2、建立院校融通的专兼教学团队。实施专业双带头人制度,专兼职教师共同承担专业理论、实践教学任务,校内生产性实训,校外顶岗实习。互聘兼职人员,互相培养在职员工。
3、开发院校合作课程,建立“优势互补、功能衔接”的校内外实训基地。院校合作分析岗位任务、项目,设计教学内容。根据医学检验技能型人才培养的特点,专兼职教师提出检验项目,指导学生分组查阅资料、设计操作方案、完成检测项目,提高学生的自主学习、实践操作及团队协作能力。校内实训基地进一步完善理实一体实训室、新建医院检验流程的仿真性实训实验基地。已建立校外5家共建实训基地和60余家顶岗实训基地。




1、校内实训基地:血液学检验现有实验实训室300平方米,集教学、培训、卫生服务于一体。
主要仪器设备:显微镜110余台、五人共览显微镜2套、互动显微镜32台学生机,2台教师机,超清晰骨髓细胞分析系统1套,血细胞分析仪半自动和五分类全自动各1套,四通道血凝仪1台。
血液学检验教学骨髓切片1000余张,包含有正常骨髓象,缺铁性贫血、巨幼细胞贫血、再生障碍性贫血、急、慢性白血病等骨髓切片。拥有一套自主建立的骨髓细胞形态图片库及考核图片库。
2、校外实训基地:医学检验技术专业学生在教学过程将赴五家共建基地进行自动化检验仪器的示教和操作,学生在此期间主要完成本课程血液流变仪、全自动血凝仪等的示教和操作的实验教学内容。
3、校外实习基地:在60余家浙江省二级甲类以上医院建立校外实习基地,医学检验技术专业学生在校外实习基地完成43周的顶岗实习。




《血液学检验》成绩由理论考核成绩(50分)+实验实训考核成绩(30分)+平时成绩(20分)组成。考评根据本课程知识目标和能力目标对必备知识点的要求,结合全国卫生专业技术资格《临床医学检验与技术》考试大纲,建立血液学检验试卷库,采用闭卷形式进行考试,由教务处考试中心统一组织。
1、在理论考核方面,建立试题或试卷库,实行“教考分离”。
2、在技能考试方面主要是骨髓细胞形态考核,结合形成性评价、实验结果、实验报告教师总体测评,注重过程性价。
3、在顶岗实习考核中,由医院检验科老师进行理论和技能的出科考试。
经过多年积累、改革和探索,血液学检验已成为检验系的一门重要核心课程。教学方法和手段多样化,循序渐进,努力创新,深受校内外专家、同事的好评,教学效果良好。课程任课老师曾获得中青年上课比赛二等奖,说课比赛三等奖,并有多位教师获得校级教学优胜奖,受到学生的欢迎。毕业后学生主要分布浙江省医学检验第一线,成为浙江省中坚力量。
1、推荐教材
血液学检验,侯振江,人民卫生出版社, 2014 第3版
血液学检验实训指导,吴宜春,浙江大学出版社,2013 第1版


2、推荐参考书
临床血液学学与检验,第4版,许文荣、王建中,人民卫生出版社,2007
现代血液形态学,卢兴国,上海科学技术出版社,2003
2014全国卫生专业技术资格考试指导临床医学检验技术,全国卫生专业技术资格考试专家委员会,人民卫生版社,2013
http://www.dxy.cn
http://www.labdd.com
http://www.clinet.com.cn
http://www.labweb.cn
http://course.jingpinke.com

原始粒细胞
早幼粒细胞
中性中幼粒细胞
中性晚幼粒细胞
中性杆状核粒细胞

中性分叶核粒细胞

嗜酸性粒细胞
嗜碱性粒细胞

原始红细胞

早幼红细胞

中幼红细胞

晚幼红细胞

原始巨核细胞

幼稚巨核细胞

颗粒型巨核细胞

产血小板型巨核细胞

裸核型巨核细胞

原始淋巴细胞

幼稚淋巴细胞
淋巴细胞
原始浆细胞

幼稚浆细胞
浆细胞

原始单核细胞
幼稚单核细胞
单核细胞

火焰细胞

海蓝细胞

尼曼-匹克细胞
| 课程章节 | | 文件类型 | | 修改时间 | | 大小 | | 备注 | |
| 2.1.1 造血器官与造血 |
文档
.pdf
|
2020-02-20 | 924.24KB | ||
| 2.1.2 造血微环境 |
附件
.${file.extension}
|
2020-02-20 | -- | ||
| 2.1.3 造血细胞的生长发育 |
文档
.pdf
|
2020-02-20 | 68.50KB | ||
| 2.1.4 骨髓细胞形态演变规律及特征 |
文档
.pdf
|
2020-02-20 | 2.25MB | ||
|
附件
.${file.extension}
|
2020-02-20 | -- | |||
| 2.2 细胞化学染色 |
文档
.pdf
|
2015-03-06 | 303.94KB | ||
| 2.2.1.1 POX视频 |
视频
.mp4
|
2015-06-29 | 707.84MB | ||
| 2.2.3 酯酶染色(SE、NSE) |
文档
.pdf
|
2015-03-06 | 523.41KB | ||
| 2.2.4 过碘酸-雪夫反应(PSA) |
文档
.pdf
|
2015-03-06 | 405.12KB | ||
| 2.2.5 中性粒细胞碱性磷酸酶染色(NAP) |
文档
.pdf
|
2015-03-06 | 765.50KB | ||
| 2.2.5.1 NAP视频 |
视频
.mp4
|
2015-06-30 | 232.28MB | ||
| 2.2.7 铁染色 |
文档
.pdf
|
2015-03-06 | 461.15KB | ||
| 3.1 贫血概述 |
文档
.pdf
|
2015-03-06 | 165.21KB | ||
| 3.1.1 贫血的分类 |
文档
.pdf
|
2015-03-06 | 252.83KB | ||
| 3.2 铁代谢障碍性贫血 |
文档
.pdf
|
2015-03-06 | 154.49KB | ||
| 3.2.2 缺铁性贫血(IDA) |
文档
.pdf
|
2015-03-06 | 716.43KB | ||
| 3.3 DNA合成障碍性贫血 |
文档
.pdf
|
2015-03-06 | 241.90KB | ||
| 3.3.2 巨幼细胞贫血(MA) |
文档
.pdf
|
2015-03-06 | 792.11KB | ||
| 3.4.1 再生障碍性贫血(AA) |
文档
.pdf
|
2015-03-06 | 462.38KB | ||
| 3.5.1.1 溶血性贫血的类型 |
文档
.pdf
|
2015-03-06 | 145.27KB | ||
| 3.5.1.2 溶血性贫血的发病机制 |
文档
.pdf
|
2015-03-06 | 340.60KB | ||
| 3.5.1.3 溶血性贫血实验室检查 |
文档
.pdf
|
2015-03-06 | 192.88KB | ||
| 3.5.2 红细胞膜缺陷的检查 |
文档
.pdf
|
2015-03-06 | 594.69KB | ||
| 3.5.3 红细胞酶缺陷的检查 |
文档
.pdf
|
2015-03-06 | 294.77KB | ||
| 3.5.4 血红蛋白异常的检查 |
文档
.pdf
|
2015-03-06 | 429.05KB | ||
| 3.5.5 免疫性溶血性贫血检查 |
文档
.pdf
|
2015-03-06 | 252.29KB | ||
| 4.1.1 急性白血病概述 |
文档
.pdf
|
2015-03-06 | 570.29KB | ||
| 4.1.4.1 慢性粒细胞白血病(CML) |
文档
.pdf
|
2015-03-06 | 581.87KB | ||
| 4.1.5.1 多发性骨髓瘤(MM) |
文档
.pdf
|
2015-03-06 | 1.06MB | ||
| 4.1.6.1 白细胞减少症和粒细胞缺乏症 |
文档
.pdf
|
2015-03-06 | 108.37KB | ||
| 4.1.6.2 类白细胞反应(LR) |
文档
.pdf
|
2015-03-06 | 276.10KB | ||
| 4.1.6.3 传染性单核细胞增多症(IM) |
文档
.pdf
|
2015-03-06 | 197.81KB | ||
| 4.1.6.5 类脂质沉积病 |
文档
.pdf
|
2015-03-06 | 334.65KB | ||
| 4.1.7 骨髓增生异常综合征(MDS) |
文档
.pdf
|
2015-03-06 | 522.62KB | ||
| 4.1.8 恶性淋巴瘤 |
文档
.pdf
|
2015-03-06 | 417.85KB | ||
| 4.1.9 骨髓憎生性疾病(MPD) |
文档
.pdf
|
2015-03-06 | 536.96KB | ||
| 4.1.10.1 恶性组织细胞病(MH) |
文档
.pdf
|
2015-03-06 | 354.40KB | ||
| 5.1.3 血液凝固及检验 |
文档
.pdf
|
2015-03-06 | 165.14KB | ||
| 5.1.5 纤维蛋白溶解系统及检验 |
文档
.pdf
|
2015-03-06 | 1.24MB | ||
| 5.1.8 APTT视频 |
视频
.mp4
|
2015-06-29 | 535.78MB | ||
| 5.2.1.2 二期止血缺陷筛选的检验 |
文档
.pdf
|
2015-03-06 | 604.18KB | ||
| 5.2.1.3 纤溶活性增强的筛选检验 |
文档
.pdf
|
2015-03-06 | 1.14MB | ||
| 5.2.2.1 过敏性紫癜 |
文档
.pdf
|
2015-03-06 | 118.94KB | ||
| 5.2.2.3 特发性血小板减少性紫癜(ITP) |
文档
.pdf
|
2015-03-06 | 115.58KB | ||
| 5.2.2.4 血友病 |
文档
.pdf
|
2015-03-06 | 122.22KB | ||
| 5.2.2.6 弥散性血管内凝血(DIC) |
文档
.pdf
|
2015-03-06 | 155.49KB | ||
| 6.1 病例1 |
视频
.mp4
|
2020-01-02 | 365.62MB | ||
| 6.2 病例2 |
视频
.mp4
|
2020-01-02 | 295.16MB | ||
| 6.3 病例3 |
视频
.mp4
|
2015-07-01 | 187.47MB |